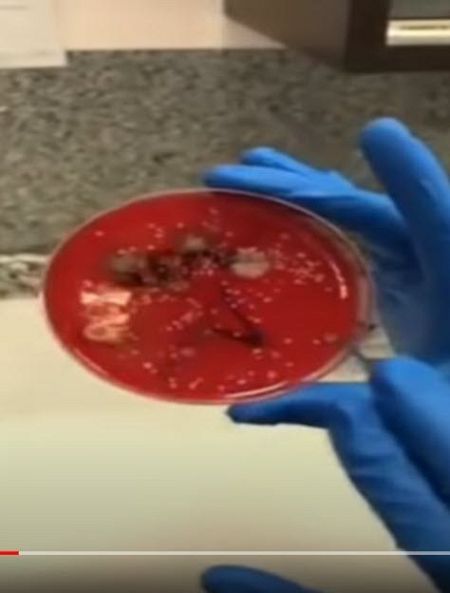
Muestra de una mascarilla utilizada tres semanas

Usadas correctamente, las mascarillas y sus bacterias no provocan infecciones ni neumonía
- Analizamos cada jornada los bulos que circulan en redes sociales sobre el coronavirus
- Escríbenos por whatsapp al 676 676 148 y verificamos por ti los mensajes que recibas
- ¿Qué es el coronavirus? | Mapa de España | Mapa mundial
- Mapa de los brotes en España | Mapa de la nueva normalidad | Qué se sabe de la vacuna
- Coronavirus: última hora en directo


Grupos conspiracionistas están impulsando un vídeo que muestra las bacterias presentes en las mascarillas para convencer de que con su uso se producen infecciones y se “obliga a enfermarlo a usted y a sus propios hijos”. Es una información engañosa, pues el vídeo parte de un experimento que solo evidencia el peligro por el mal uso o la reutilización excesiva de estos productos.
La grabación, que se ha hecho viral, pertenece a la farmacéutica Marisa García Alonso, propietaria de la clínica de análisis EAAC en Boadilla del Monte (Madrid). García Alonso la ha publicado en su cuenta de Instagram pero en dos partes, lo que ha propiciado que grupos antimascarillas utilicen solo la segunda, la que describe sobre todo el resultado del experimento.
En un canal de YouTube de información alternativa se usa ese fragmento y se afirma: “Entenderá usted ahora fácilmente por qué se están dando casos de pleuresía pulmonar y neumonía que irán lógicamente en aumento mientras transcurran más y más días con esas mascarillas con las que su gobierno le obliga a enfermarlo a usted y a sus propios hijos”. Se añade que: “Están obligando a enfermar y a inmunodeprimir a personas sanas” y una coletilla habitual en estas fuentes: “Usted no lo verá en los medios de comunicación oficial”. En un grupo anti-vacunas de Telegram se ha hecho circular también esa segunda parte del vídeo con un “OJO con el uso de mascarillas” y etiquetas contra las vacunas, el 5G y el llamado “nuevo orden mundial” (teorías de la conspiración).
Visto desde el inicio, el vídeo muestra que García Alonso realiza la prueba porque una compañera se lo ha pedido tras tener “una infección en la garganta a raíz de usar mucho la mascarilla”. Ha metido en una estufa cinco placas de Petri. Son pequeños recipientes de cristal no herméticos que permiten observar cómo crecen microorganismos en su interior. Se coloca dentro una sustancia nutriente, se añade una muestra a estudio, se aplica calor y se espera para ver el desarrollo. En este caso la sustancia es roja porque el nutriente es agar sangre. El agar procede de las algas y es gelatinoso y la sangre ovina se añade para observar mejor las características del microorganismo.
Allí donde se observa un conjunto preocupante de bacterias no se han seguido los consejos que ya te explicamos en el artículo “¿Cómo lavo mi mascarilla?” y que transmite el Ministerio de Sanidad, ya sea en su documento “Limpieza y desinfección de mascarillas higiénicas reutilizables” o en sus Recomendaciones sobre el uso de mascarillas en la Comunidad en el contexto del COVID-19 .
Siempre hay que tener en cuenta dos consejos principales: a) el uso recomendable para las mascarillas es de 4 horas (por lo general, los expertos y las farmacias citan hasta 8-10 como aceptables) y b) siempre hay que leer la etiqueta del fabricante para saber si el producto se puede lavar/reutilizar o no.
Mascarillas higiénicas, quirúrgicas y autofiltrantes
La primera muestra del vídeo es una mascarilla de tela (del tipo “higiénica reutilizable”) usada un día para ir a cantar a un coro. Tiene estafilococos, probablemente contaminantes y bacterias “por determinar”. Conforme a las indicaciones del Ministerio de Sanidad, este tipo de protector debería lavarse a altas temperaturas (entre 60º y 90º) antes de volver a ser utilizado, precisamente para eliminar cualquier foco de infección.
La segunda mascarilla tiene forma de FFP2 (tipo “autofiltrante”). La protagonista la lleva en el bolso y la usa intermitentemente cuando le piden que se ponga una: “Tiene unos cuantos estafilococos y no tiene demasiada contaminación”. Según explicó la Asociación de Empresas de Equipos de Protección Individual (ASEPAL) a Verifica RTVE, ningún fabricante de este tipo de protectores recomienda su reutilización salvo que puedan cambiarse sus filtros y explícitamente lo indique la etiqueta.
Muestra de una mascarilla utilizada tres semanas VERIFICA RTVE
Por otra parte, llevar las mascarillas en el codo (como se menciona en el vídeo), en la frente o en otros lugares del cuerpo tampoco es recomendable, y hay pautas para el guardado. Según Sanidad: “En caso de ser imprescindible realizar de manera muy puntual un uso intermitente de la mascarilla, se debe extremar la higiene de manos al quitarla y ponerla, y se debe almacenar en un recipiente o bolsa de papel limpios, colocándola de manera que no se contamine la parte interior que va a estar en contacto con la cara”. Para envolverlas es más recomendable el papel o la tela que el plástico, pues el primero es material deshidratante y protege mejor, mientras el segundo acumula la humedad y puede crear hongos.
La tercera y cuarta muestras parecen de mascarillas de tipo quirúrgico, con pliegues. Se trata de una nueva que ha generado muy pocas colonias pero no está ya “estéril”, subraya García Alonso, y otra que es la que ella misma llevaba al inicio del vídeo y que tiene estafilococos, estreptococos y alguna bacteria. Francisco Esteban Ruiz, profesor titular de Biología Celular de Jaén, nos explicó que las mascarillas quirúrgicas “deben desecharse después de su uso y no deberían lavarse ni re-esterilizarse, ya que el material del que están hechas se alteran. Así suele indicarse en las especificaciones técnicas”.
La quinta y última muestra pertenece de nuevo a una mascarilla FFP2 usada durante tres semanas y 8 horas cada día. Presenta muchas manchas (estafilococos, estreptococos…) y la farmacéutica la describe así: “Está tan llena de bichos que no sabemos qué hay aquí”. Como se ha explicado, este tipo de mascarilla, salvo que lo indique el fabricante, no se debe reutilizar.
Cuidado con la reutilización
Hemos hablado con la protagonista del vídeo original, García Alonso. Dice que la están criticando desde grupos anti mascarilla y pro mascarilla pero que ella ha utilizado mascarilla muchas veces en su trabajo habitual y que su única intención era demostrar que el uso prolongado de estos elementos sobre nuestros rostros “puede llegar a producir infecciones bacterianas por sobre exposición de las mismas”. En esta pieza para el Canal 24 Horas TVE, cuenta que le han llegado casos de patologías dérmicas, sinusitis, otitis o infección de garganta “si mantenemos un sobrecrecimiento de bacterias en la zona nasal oral”.
Mar Tomás, portavoz de la Sociedad Española de Enfermedades Infecciosas, insiste a Verifica RTVE que recordemos a los lectores el mensaje principal: “Es importante seguir las condiciones de higiene recomendadas”. Esta microbióloga del Hospital de A Coruña nos explica que “no se ha descrito que la frecuencia en la utilización de mascarillas de forma adecuada se asocie a un incremento de infecciones bacterianas”, es decir, no existe literatura científica que muestre peligro en caso de uso correcto. Si las mascarillas se utilizan bien, “con las medidas higiénicas aconsejadas por las guías clínicas, con un recambio frecuente en el caso de mascarillas quirúrgicas, el riesgo de infección es mínimo”.

Marisa García Alonso, en el vídeo original VERIFICA RTVE
David de la Rosa, coordinador de Tuberculosis e Infecciones respiratorias de la Sociedad Española de Neumología (SEPAR), ofrece explicaciones similares: “Algunas mascarillas están hechas de material sensible que puede retener los microorganismos. Pero de ahí a sugerir que provoquen un mayor riesgo de neumonía, eso no está demostrado. Lo que pasa es que la gente se las pone durante semanas, se ensucian y pierden propiedades. Ocho o diez horas máximo, y si se usan a ratitos, un par o de tres de días como mucho, eso es lo aconsejable”.
García Alonso cree que debería informarse bien a la gente y que estos elementos han de usarse con sentido común, no todo el día “de la mañana a la noche” sin permitir una buena aireación. Recomienda “cambiarlas, desinfectarlas o lavarlas (según el modelo de mascarilla) mínimo una vez al día, dependiendo del uso que se les dé”. Hay personas, nos comenta, que utilizan las mascarillas autofiltrantes, destinadas en realidad a personal médico, pensando que su protección es mayor, pero si se va a dar una reutilización, haciendo que pierdan propiedades, es mejor optar por las de tela, que se pueden lavar.
Sobre los llamativos agentes infecciosos que aparecen en las placas, Tomás precisa: “Las bacterias comentadas en el vídeo son flora normal de la piel y/o incluso orales y no producen patologías si no se encuentran en un condiciones y cantidad determinada”. García Alonso también aclara que “convivimos con bacterias y están por todas partes. En la boca hay cientos de ellas. Por eso es importante que la tengamos bien higienizada”. Para De la Rosa: “Vivimos rodeados de bacterias. Si hiciéramos esa prueba con nuestra propia boca, saldrían muchas más. Y si lo ponemos en la balanza, la opción de no usar la mascarilla supone la posibilidad de contagiarnos del coronavirus. Parece evidente la elección adecuada”.
Verifica RTVE considera que, a día de hoy, no existen pruebas científicas que vinculen las mascarillas, correctamente utilizadas, con infecciones bacterianas o neumonía, como sugiere el canal de YouTube mencionado al inicio de este texto. Su información distorsiona la neutralidad del videoexperimento original y es engañosa.




